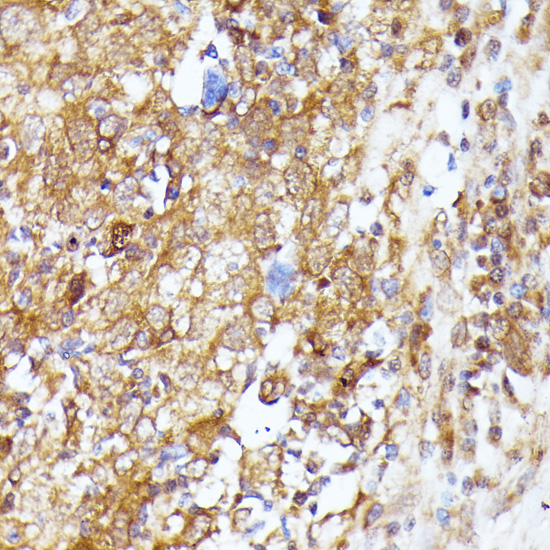

Filters
Clonality
Type
Reactivity
Gene Name
Isotype
Host
Application
Clone
7106 results for " Mouse" - showing 1450-1500
TFEB, Polyclonal Antibody (Cat# AAA22060)
calcitonin-related polypeptide alpha, ELISA Kit (Cat# AAA15418)
Insulin (INS), ELISA Kit (Cat# AAA23116)
PDK2, Monoclonal Antibody (Cat# AAA25930)
Megalin, Monoclonal Antibody (Cat# AAA14941)
met proto-oncogene (hepatocyte growth factor receptor), ELISA Kit (Cat# AAA15709)
Mitochondrial uncoupling protein 2 (UCP2), ELISA Kit (Cat# AAA27251)
CCDC59, Polyclonal Antibody (Cat# AAA29808)
MOG, ELISA Kit (Cat# AAA21622)
Pulmonary Surfactant Associated Protein C, ELISA Kit (Cat# AAA16495)
CDH16, Polyclonal Antibody (Cat# AAA28211)
Mitochondrial uncoupling protein 3 (UCP3), ELISA Kit (Cat# AAA27186)
Apolipoprotein B, ELISA Kit (Cat# AAA17736)
GAB2, Monoclonal Antibody (Cat# AAA14150)
STK33, Monoclonal Antibody (Cat# AAA25922)
MTA1, Monoclonal Antibody (Cat# AAA26178)
CDKN1A, Polyclonal Antibody (Cat# AAA28244)
fibronectin type III domain containing 5, ELISA Kit (Cat# AAA18010)
PCAF, Monoclonal Antibody (Cat# AAA25944)
Interleukin 15 (IL15), ELISA Kit (Cat# AAA22888)
PCAF, Monoclonal Antibody (Cat# AAA26474)
Cyclooxygenase 2, ELISA Kit (Cat# AAA15997)
EGF-like-domain, multiple 6, ELISA Kit (Cat# AAA18049)
fibroblast growth factor 1 (acidic), ELISA Kit (Cat# AAA14978)
peptidylprolyl isomerase B (cyclophilin B), ELISA Kit (Cat# AAA18296)
KAT2A, Polyclonal Antibody (Cat# AAA29826)
UBE2L3, Polyclonal Antibody (Cat# AAA29829)
follistatin-like 1, ELISA Kit (Cat# AAA18055)
CLNS1A, Polyclonal Antibody (Cat# AAA28292)
ACTB, Monoclonal Antibody (Cat# AAA25992)
RNPS1, Monoclonal Antibody (Cat# AAA26254)
Integrin, beta1, Monoclonal Antibody (Cat# AAA26763)
Deoxyribonuclease I, ELISA Kit (Cat# AAA16279)
Integrin, beta1, Monoclonal Antibody (Cat# AAA26773)
Fatty-acid amide hydrolase 1 (FAAH), ELISA Kit (Cat# AAA27285)
GSTA1, Polyclonal Antibody (Cat# AAA22171)
Acidic mammalian chitinase (CHIA), ELISA Kit (Cat# AAA27297)
KLF10, Monoclonal Antibody (Cat# AAA26268)
Integrin, beta1, Monoclonal Antibody (Cat# AAA26801)
Inhibin Beta C (INHbC), ELISA Kit (Cat# AAA20401)
SPP1, Monoclonal Antibody (Cat# AAA26038)
RAB33B, Monoclonal Antibody (Cat# AAA14775)
Purified by Protein A affinity chromatography.